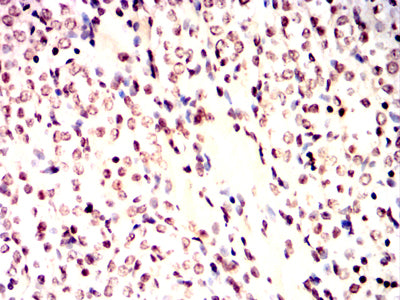

Mouse Monoclonal Antibody to ATM
货号:
32439
别名:
AT1; ATA; ATC; ATD; ATE; ATDC; TEL1; TELO1
应用:
IHC,FCM
反应种属:
抗体类型:
Primary antibody
Swissprot:
Q13315
规格:
目录价
在线咨询
Description |
|---|
The protein encoded by this gene belongs to the PI3/PI4-kinase family. This protein is an important cell cycle checkpoint kinase that phosphorylates; thus, it functions as a regulator of a wide variety of downstream proteins, including tumor suppressor proteins p53 and BRCA1, checkpoint kinase CHK2, checkpoint proteins RAD17 and RAD9, and DNA repair protein NBS1. This protein and the closely related kinase ATR are thought to be master controllers of cell cycle checkpoint signaling pathways that are required for cell response to DNA damage and for genome stability. Mutations in this gene are associated with ataxia telangiectasia, an autosomal recessive disorder. |
References |
|---|
| MC Cancer. 2021 Jan 5;21(1):27. Fam Cancer. 2022 Apr;21(2):211-227. |
Specification |
|
|---|---|
| Aliases | AT1; ATA; ATC; ATD; ATE; ATDC; TEL1; TELO1 |
| Entrez GeneID | 472 |
| Swissprot | Q13315 |
| clone | 2A7A10 |
| WB Predicted band size | 350.7kDa |
| Host/Isotype | Mouse IgG2a |
| Antibody Type | Primary antibody |
| Storage | Store at 4°C short term. Aliquot and store at -20°C long term. Avoid freeze/thaw cycles. |
| Immunogen | Purified recombinant fragment of human ATM (AA: 2577-3056) expressed in E. Coli. |
| Formulation | Purified antibody in PBS with 0.05% sodium azide |
Application |
|
|---|---|
| IHC | 1/200 - 1/1000 |
| FCM | 1/200 - 1/400 |
| ELISA | 1/10000 |
Product Image
-
Black line: Control Antigen (100 ng);Purple line: Antigen (10ng); Blue line: Antigen (50 ng); Red line:Antigen (100 ng)

-
Flow cytometric analysis of Hela cells using ATM mouse mAb (green) and negative control (red).

-
Flow cytometric analysis of COS-7 cells using ATM mouse mAb (green) and negative control (red).

-
Immunohistochemical analysis of paraffin-embedded human bladder tissues using ATM mouse mAb with DAB staining.

-
Immunohistochemical analysis of paraffin-embedded human gastric cancer tissues using ATM mouse mAb with DAB staining.

-
Immunohistochemical analysis of paraffin-embedded Mouse liver tissues using ATM mouse mAb with DAB staining.

-
Immunohistochemical analysis of paraffin-embedded Rat kidney tissues using ATM mouse mAb with DAB staining.

-
Immunohistochemical analysis of paraffin-embedded Rabbit liver tissues using ATM mouse mAb with DAB staining.

鄂公网安备42018502007531号
鄂公网安备42018502007531号

